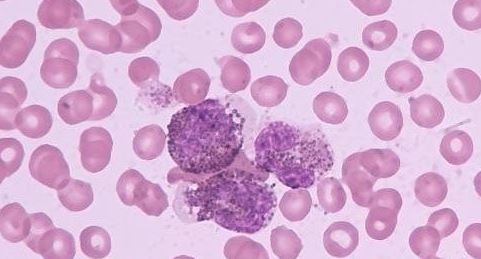
Cancer Res：白血病干细胞的致命弱点

你现在所在位置:资讯首页 > 专题讲座

Am J Pathol:母乳可以预防新生儿患致命疾病
对于婴儿来说,母乳是其他事物无法比拟的最重要的事物。母乳不但可以提供婴儿生长所需的全部营养,更加神奇的是,在婴儿不同的成长发育...
分类:专题讲座

JACC:梨型身材更健康
近日,国际杂志Journal of the American College of Cardiology上刊登的一篇论文中,来自德州大学西南医学中心的研究人员通过研究认...
分类:专题讲座

JVI:编辑HPV病毒基因可以导致癌细胞的自我毁灭
杜克大学的科学家们利用基因组编辑工具CRISPR可以有选择性地破坏负责宫颈癌细胞生存和生长的两种乳头瘤病毒(HPV)基因,从而引发癌细...
分类:专题讲座

Sci Rep:狼疮抗体或可摧毁癌细胞
近日,刊登于国际杂志Scientific Reports上的一片文章,耶鲁大学癌症研究中心的研究人员研究发现狼疮抗体或许可以摧毁癌细胞。此项研...
分类:专题讲座

Am J Clin Nutr:维生素D或许并不会降低心脏病和中风的风险
近日,刊登于国际杂志Am J Clin Nutr上一篇论文中东安格利亚大学的研究人员通过研究发现,维生素D片并不能够避免心脏病和中风的发生...
分类:专题讲座

Cell Rep:肿瘤细胞可协作促进恶性黑色素瘤扩散
在国际杂志Cell Reports上的一篇研究论文中,曼彻斯特大学的研究人员表示,皮肤癌细胞可以通过互相合作来实现在机体中的快速扩散,尤其...
分类:专题讲座

黄蜂毒液显示治疗乳腺癌的潜力
Journal of Controlled Release杂志上的一篇文章显示,Institute for Biomedical Research (IRB Barcelona)科学家利用体外试验发现...
分类:专题讲座
Cancer Res:白血病干细胞的致命弱点
国际杂志Cancer Research上的一篇研究论文中,来自歌德大学(Goethe-Universitat Frankfurt am Main)的研究人员通过研究发现了急性...
分类:专题讲座

PNAS:大脑内葡萄糖控制开关研究或可加速糖尿病靶向疗法的开发
Proceedings of the National Academies of Sciences杂志上的一篇研究论文显示,来自耶鲁大学医学院的研究人员发现大脑中存在一种...
分类:专题讲座






